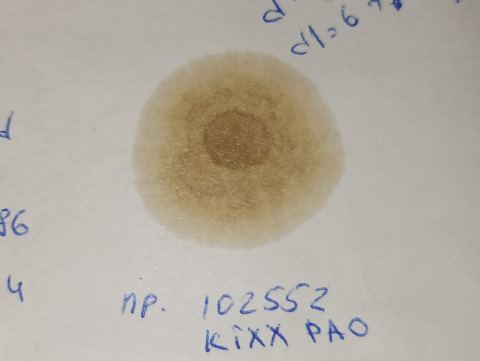

Запчасти
Уплотнительное кольцо, резьбовая пробка маслосливн. отверст.
Характеристики детали



- Производитель
- CORTECO
- Артикул
-
402129H - Название
- Уплотнительное кольцо, резьбовая пробка маслосливн. отверст.
- Аналоги
- 15 кроссов
- Фотографии
- 50 фото
- Упоминания в блогах
- 511 записей
- Оригинальная продукция Прямые контракты с производителями
- В наличии на все марки авто 1,5 млн наименований запчастей
- По всей России 145 городов с магазинами и складами
Аналоги 15
Производитель
Артикул
Отзывы
Упоминания в блогах 512
Volkswagen Polo Sedan
Volkswagen Jetta VI
Volkswagen Polo Sedan